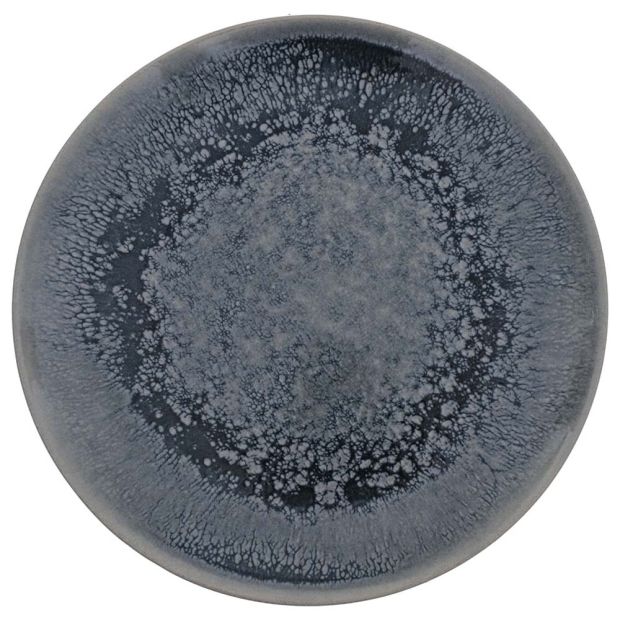
main product photo

Налично
Ном. №
21212040009
ДЕСЕРТНА ЧИНИЯ Ф20 CM 21212040009
(0)
Оцени продукта
Специална цена
2,49 € / 4,87 лв.
вместо
3,57 € / 6,98 лв.
спестяваш
1,08 € / 2,11 лв.
Валутен курс: 1 EUR = 1.95583 BGN
Цената е с вкл.ДДС
Валидно до 12.07.2026
Срок на доставка до 10.07.2026
Лесно и сигурно плащане
14 дни право на връщане за онлайн поръчки
Описание
Технически характеристики
- Тегло (кг.): 0,373
- Основни цветове в артикула: СИН
- Брой пакети: 1
- Материал: КЕРАМИКА
-
Размери в см.:
20/20
- Налични за онлайн покупка: Да
- Само онлайн: Не
Отзиви
Плащане и доставка
Услуги
Наличност по магазини
Лизингов калкулатор
Популярни търсения
Качествени продукти
Винаги изгодни цени
Транспорт до вашия дом
14 дни право на отказ
Безопасно пазаруване